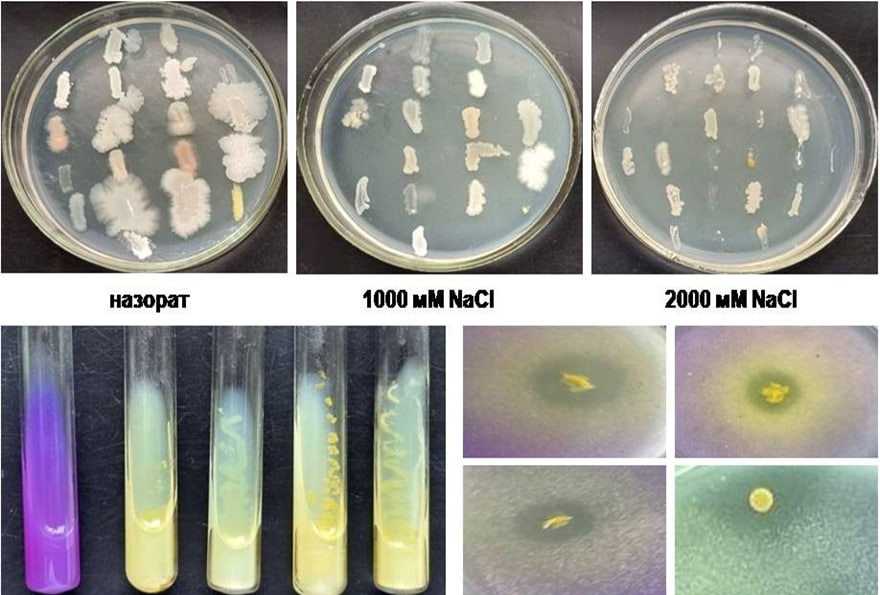
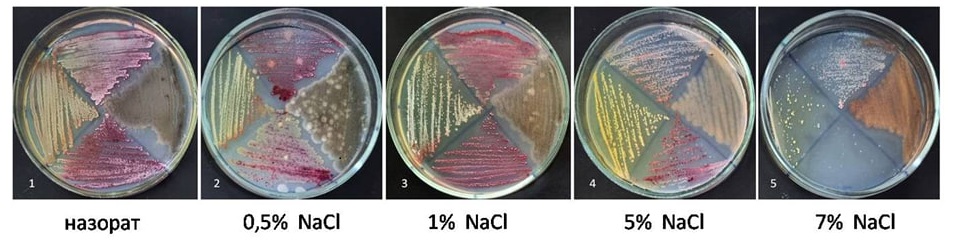

Bugungi kunda shoʻrlanish va tuproq degradatsiyasi qishloq xoʻjaligining eng katta muammolaridan biriga aylanmoqda. Ayniqsa, qurgʻoqchil hududlarda hosildorlik pasayib, tuproqning tabiiy unumdorligi yoʻqolmoqda.
Shu muammoga javob sifatida Fanlar akademiyasi Mikrobiologiya instituti olimlari tomonidan shoʻrga chidamli tuproq mikroorganizmlari kolleksiyasi yaratildi. Kolleksiya shoʻrlangan tuproqlardan ajratib olingan 30 dan ortiq mahalliy, yuqori tuz konsentratsiyasiga chidamli shtammlarni oʻz ichiga oladi.

Ushbu mikroorganizmlar:
Kolleksiya asosida ishlab chiqiladigan biooʻgʻitlar ekologik xavfsiz boʻlib, kimyoviy oʻgʻitlarga boʻlgan ehtiyojni kamaytiradi. Ular degradatsiyaga uchragan yerlarni qayta tiklash, tuproq shoʻrlanishini pasaytirish va hosildorlikni oshirish imkonini beradi.
Shoʻrga chidamli mikroorganizmlar kolleksiyasi — bu strategik milliy resurs boʻlib, unga kiritilgan har bir investitsiya barqaror qishloq xoʻjaligi va oziq-ovqat xavfsizligiga qaratilgan qadamdir.